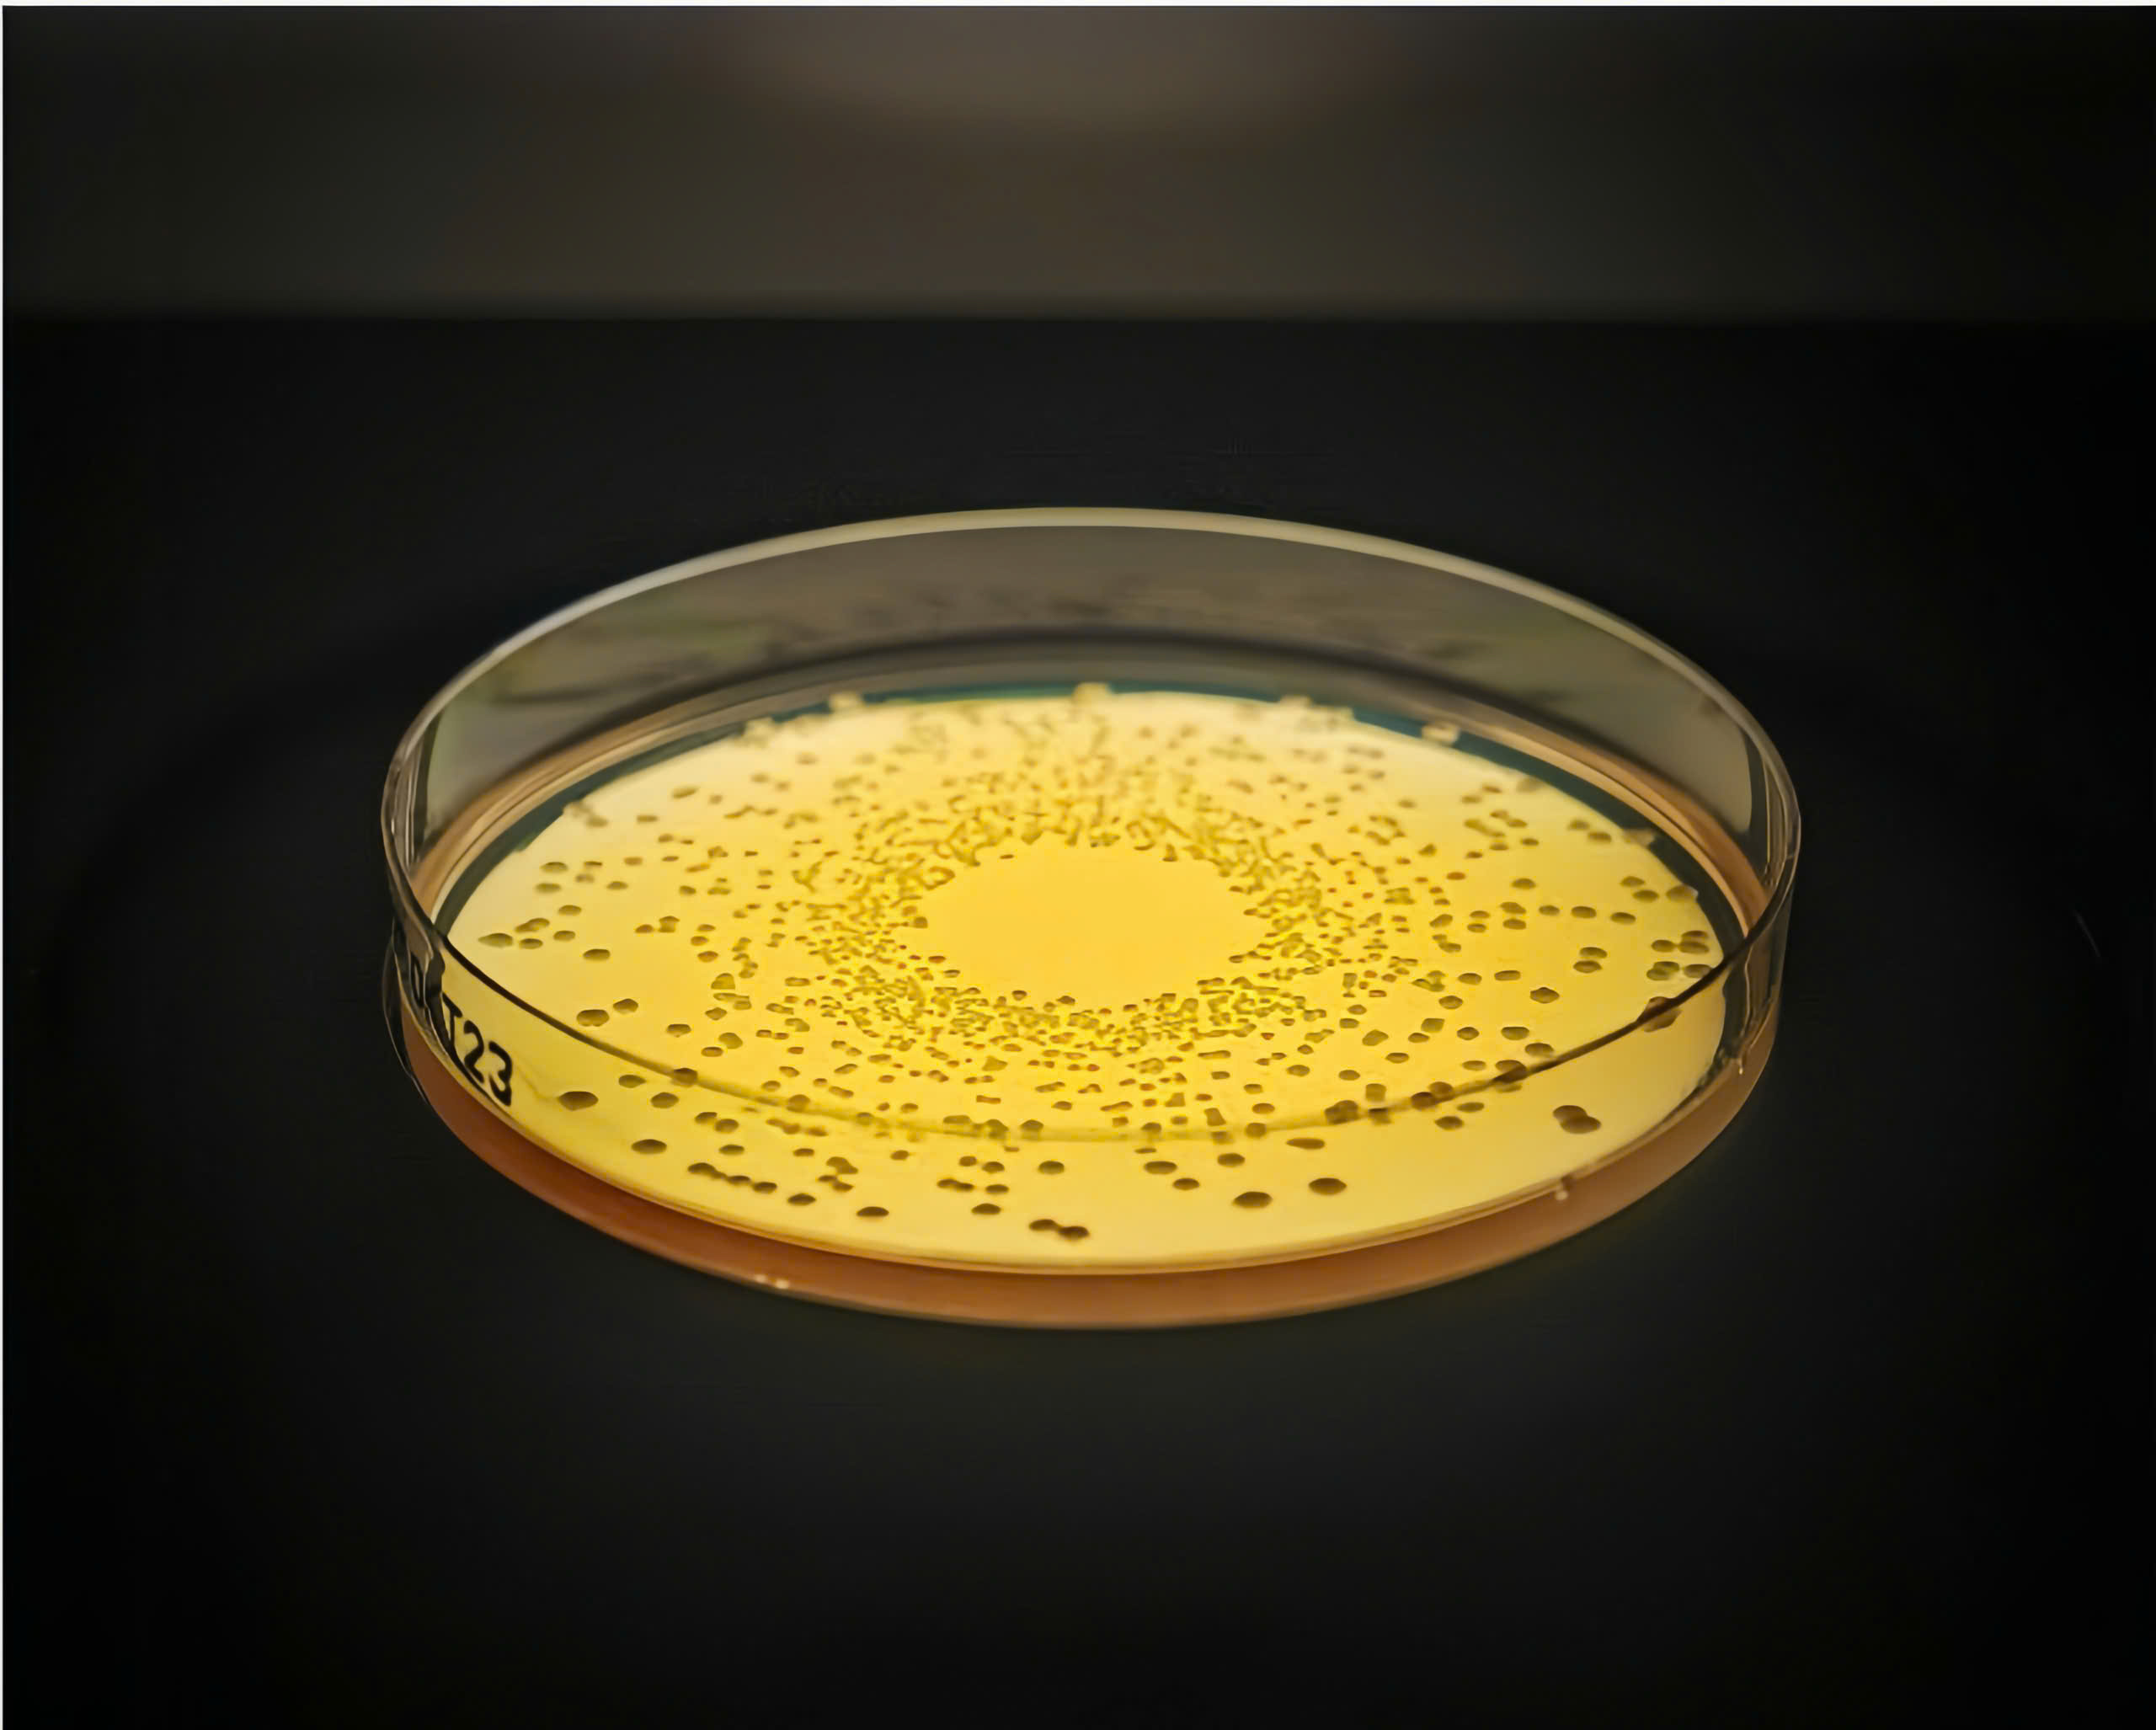
z7244838535947_d186e8b3957d860d710d125c44e9e7da

DẪN ĐẦU THẾ GIỚI VỀ PROBIOTIC
BioGaia là thương hiệu được thành lập vào năm 1990 tại Thụy Điển, là công ty tiên phong đầu tiên trong lĩnh vực chế phẩm sinh học.
Cho đến nay, đã có hơn 30 năm nghiên cứu phát triển đổi mới nhưng BioGaia vẫn giữ nguyên vị thế dẫn đầu thế giới về Probiotic.

MẠNG LƯỚI NGHIÊN CỨU LÂM SÀNG SÂU RỘNG
Nhờ những nỗ lực không ngừng nghỉ, BioGaia đã xây dựng thành công một mạng lưới chuyên gia đặc biệt gồm 50 viện nghiên cứu và phòng khám không chỉ nghiên cứu hiệu quả của L.reuteri đối với các chỉ định khác nhau mà còn cả cách thức và cơ chế lợi khuẩn này hoạt động.
BioGaia hợp tác nghiên cứu với các trường đại học và bệnh viện trên khắp thế giới, như Đại học Khoa học Nông nghiệp Thụy Điển ở Uppsala, Thụy Điển, Viện Karolinska ở Stockholm, Thụy Điển, Bệnh viện Đại học Sahlgrenska ở Gothenburg, Thụy Điển, Bệnh viện Nhi Texas ở Hoa Kỳ và Bệnh viện Đại học Bari và Turin ở Ý.
MỞ RỘNG TẦM ẢNH HƯỞNG TRÊN THẾ GIỚI
Nhờ những phát minh có tính đột phá về chế phẩm sinh học, cũng như những kết quả nghiên cứu lâm sàng chứng minh hiệu quả và an toàn của BioGaia mang lại đối với người sử dụng. BioGaia đã mở rộng tầm ảnh hưởng sản phẩm đến hơn 100 quốc gia trên thế giới.
Cho đến nay, sản phẩm của BioGaia được khuyến khích sử dụng bởi nhiều bác sĩ nhi khoa và chuyên gia y tế.


ĐÓNG GÓP CHO XÃ HỘI
Năm 2017, BioGaia thành lập Quỹ ngăn chặn tình trạng kháng thuốc kháng sinh, hay còn được gọi là Quỹ PAR là một tổ chức độc lập với mục đích ngăn ngừa tình trạng kháng thuốc kháng sinh thông qua hỗ trợ các hoạt động nghiên cứu, giáo dục và thông tin.
CHIẾN LƯỢC PHÁT TRIỂN TRONG TƯƠNG LAI
Tầm nhìn trong tương lai của BioGaia là sẽ tiếp tục trở thành một công ty dẫn đầu thế giới về chế phẩm sinh học đồng thời đóng góp cải thiện và nâng cao sức khỏe của hàng triệu người dân trên toàn thế giới bằng cách cung cấp các sản phẩm men vi sinh đã được chứng minh lâm sàng mang lại hiệu quả và an toàn trên người sử dụng.
